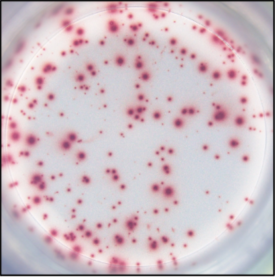
新闻图片10

上海优宁维生物科技股份有限公司代理商
19 年
手机商铺
- NaN
- 0
- 0
- 2
- 2
公司新闻/正文
酶联/荧光免疫斑点分析技术常见问题解答
913 人阅读发布时间:2023-01-28 10:51
一 ELISPOT(酶联免疫斑点技术)/FluoroSpot(荧光免疫斑点技术)的区别

ELISPOT(酶联免疫斑点技术)

FluoroSpot(荧光免疫斑点技术)
FluoroSpot是在ELISpot基础上发展起来的,使用荧光检测代替比色法。荧光免疫斑点实验结合了ELISpot的灵敏性和同时分析几种分析物分泌的能力,适用于单次检测和大规模筛选不同功能特征的细胞群检测。荧光免疫斑点实验是将夹心法与荧光标记检测法相结合,对同一孔内的两种或多种分析物进行检测。

案例说明:通过ELISpot和FluoroSpot分析检测分析食蟹猕猴外周血单个核细胞(PBMC)分泌的IFN-γ和IL-2。PBMC仅在培养基中孵育过夜,或用恒河猴巨细胞病毒pp65或抗cd3单抗刺激。
A) ELISpot:使用单抗组合MT126L和7-b6-1-生物素和IL-2使用单抗组合MTA91/MT2C95和MT8g10-生物素进行分析。
B)FluoroSpot:IFN-γ和IL-2使用与ELISpot相同的抗体,但在相同的井中。所示图像代表了490/550的IFN- γ响应,以及550/570 nm的IL-2响应。图中还显示了IFN-γ和IL-2图像(IFN-γ + IL-2)的计算机覆盖分析,其中双产生细胞显示为黄色斑点。实验重复进行,结果具有可重复性。
二 ELISPOT(酶联免疫斑点技术)相关问题答疑
ELISPOT(酶联免疫斑点技术)是一种基于ELISA基本原理建立的、高灵敏的细胞因子方法,能够对抗原刺激后的活细胞进行功能性检测,具有较髙的特异性、直观可信度髙,并且易操作,已被广泛用于细胞因子分泌细胞(CK)或抗体分泌细胞(ASC)测定中,在国内外免疫学界获得了广泛的应用。

该检测技术主要的分析步骤有:样本制备、包被单抗、细胞+抗原刺激+孵育、检测抗体的加入与孵育、显色与读板。本期就结合以上主要操作流程,对常见的ELISPOT应用中常见的问题进行分析与解答。
1. 样本制备
1.1 可检测的细胞类型有哪些?
原则上,任何可以分泌蛋白质的细胞都可以进行检测:
贴壁细胞在进行检测步骤之前,需要进行裂解步骤,以从ELISPOT板上去除所有细胞;
新鲜和冷冻保存的PBMC都可用于ELISPOT和FluoroSpot分析;
对于T细胞,强烈建议使用新鲜的啮齿动物脾脏细胞进行测定,因为该细胞的冷冻保存过程太复杂,并且冷冻保存对脾细胞活力和功能有负面影响。
目前主要用于鉴定:抗原激活分泌细胞因子的T细胞,外周血&脾脏细胞中分泌抗体的B细胞。

1.2 可以检测哪些品种的样本?
需要确定待测物种是否能产生想要研究的细胞因子,一些动物样本只有在体内受到适当抗原刺激后,才会分泌细胞因子。ELISPOT是体外检测,故而可能不满足一些特定的分泌条件。

1.3 血液储存及运输条件
全血样本应在室温(20-26℃)条件下,储存不超过8小时;
抗凝血剂推荐肝素+柠檬酸盐,这两种物质,在测定中没有报告对细胞功能的不利影响。
不推荐EDTA(EDTA通过钙螯合抑制凝血,钙螯合在抗原特异性再刺激期间损害细胞因子诱导)。

图片来源:百度图片
1.4 使用PBMC样本进行检测时,有哪些需要注意的事项?
首先,单核细胞作为T细胞的抗原递呈细胞(APC)至关重要,单核细胞数量过少会导致T细胞ELISPOT/FluoroSpot测定中的斑点数降低,特别是冷冻保存的样本
,因此需补充单核细胞。
其次,PBMC制剂中死细胞的存在会影响T细胞与B细胞的测定结果,建议在样本制备时,进行细胞计数并计算细胞活率。细胞活率大于80%的样本即可进行检测,否则由于操作过程中的损失及自然凋亡,最后检测时形成的斑点数也会减少。
人IFN-γ T细胞ELISPOT结果示例(银染):2x105PBMC/孔

单核细胞耗尽样品

正常样品
图片来源:www.ucytech.com
2. 单抗包被
2.1 适合进行ELISPOT检测的抗体有哪些?
在 ELISA 系统中最适合的一抗和二抗并不意味着这些抗体也是 ELISPOT 测定的最佳抗体。ELISPOT抗体对由制造商在广泛的优化和验证的基础上选择,并应用作ELISPOT测定的匹配抗体对。
优宁维推荐-ELISPOT检测爆款试剂盒
| 货号 | 产品名称 | 规格 | | 货号 | 产品名称 | 规格 |
| LX-551873 | Hu IFN-Gma ELISPOT Pair | lOPlates | LX-551881 | Ms IFN-Gma ELISPOT Pair | lOPlates |
| LX-551884 | Hu IL-2 ELISPOT Pair | lOPlates | LX-551876 | Ms IL-2 ELISPOT Pair | lOPlates |
| LX-51885 | Hu IL-4 ELISPOT Pair | lOPlates | LX-551878 | Ms IL-4 ELISPOT Pair | lOPlates |
| LX-551886 | Hu IL-5 ELISPOT Pair | lOPlates | LX-551880 | Ms IL-5 ELISPOT Pair | lOPlates |
| LX-551883 | Hu IL-10 ELISPOT Pair | lOPlates | LX-552567 | Ms IL-6 ELISPOT Set lOPlt | lOPlates |
| LX-552574 | Hu IL-12 p70 ELISPOT Set lOPlt | lOPlates | LX-557982 | Ms IL-10 ELISPOT Pair | lOPlates |
| LX-551882 | Hu TNF ELISPOT Pair | lOPlates | LX-551875 | Ms TNF ELISPOT Pair | lOPlates |
2.2抗体包被耗时多久?
包被好的检测板,需放置在加湿室(卡盒塑料容器,底部有湿纸巾),4℃的条件下过夜保存。
2.3抗体包被应在何时进行?
抗体的包被可以提前7天进行,涂覆后使用无菌PSB洗涤,并用封闭溶液进行封闭。使用封板摸密封的ELISPOT板应及时储存在4℃,防止蒸发,若需长时间保存,则应保证环境无菌。
2.4 包被结束后各种试剂如何保存?
封闭液可以在室温放置数小时,或者4℃保存
检测抗体在室温下放置2小时,或者4℃保存
偶联物需避光保存,室温下放置1小时,或者4℃保存
3. 细胞+抗原刺激+预孵育
3.1 单孔需添加的细胞数量建议值?
ELISPOT和FluoroSpot检测的灵敏度在很大程度上取决于细胞密度。
细胞数量是否太少,则不足以获得最佳反应;过多的细胞会导致单个斑点重叠和高背景染色。
因此我们建议,在添加细胞样本之前进行细胞计数,保证细胞密度不超过3x10E5/mL 。
人IgG B细胞ELISPOT结果示例(酶染色):
在体外预孵育步骤中用IL-2和R848激活记忆B细胞。
显示:IgG分泌细胞的总数。
5x10E3个斑点

5x10E5个斑点(太多斑点无法计数)
图片来源:www.ucytech.com
3.2 刺激后的孵育时间需要多久?
一般来说,孵育的时间在12-48h之间,建议是在16h左右,也需根据细胞因子免疫反应强度来判断:如果免疫反应较强,则孵育12h;若反应较弱,则孵育48h。此外应注意,长时间的孵育(48h-72h)可能会导致板底PVDF膜渗漏。
T细胞ELISPOT检测:
当使用全长蛋白质或长肽用作为ELISPOT测定中的刺激物,且细胞密度>10E6/well/mL时,可能需要24-42小时的孵育。
小(合成)肽(8-12聚体)可以由APC直接呈递给CD8+细胞,因此不需要预育步骤。
B细胞ELISPOT检测:
静止记忆B细胞在体内不会产生大量抗体。因此,在高细胞密度(>10E6cell/well/mL)的条件下,根据细胞类型的不同,所需的预孵育时间在2-5天左右。
3.3如何设置合理的对照?
阳性对照——细胞经特异性抗原或多克隆抗体刺激 用来确定试剂盒正常工作,细胞功能完整;排除假阴性结果
阴性对照——细胞不经刺激 用来确定自发分泌因子的细胞个数;排除假阳性结果
背景对照——不加细胞和其他所有试剂 用来排除试剂或其他介质的影响产生的斑点;排除假阳性结果

图片来源:www.bio-review.com
3.4完成加样及刺激后,单孔的体积是多少?
在结束细胞铺板与抗原刺激后,需确认并检查整个实验的体系是否正确,包括溶液的体积、标签及排布,其中单孔体积(总计200μ)应包含:100μL单细胞悬液,100μL抗原刺激物。
3.4使用具有传染性病的原体时,如何对细胞板进行净化?
如果附有PVDF膜的ELISPOT板中,发生了污染,诸如包膜病毒(例如HIV,SIV)的感染因子,则可以在shou选的细胞孵育时间后对孔进行去污,。
首先从孔中吸取出细胞,然后用加了300μl4%多聚甲醛的PBS洗涤5次 ,然后在室温(20-26°C)下孵育,<5分钟,之后ELISPOT板可以继续进行其他的清洗步骤。
这些清洗步骤可能导致略高的背景染色,但对T细胞ELISPOT测定中的斑点数量和大小不会产生不利影响。
3.5 在孵育时,培养箱容积不足,可以堆叠放置ELISPOT板吗?
不可以,堆叠拜访可能会造成单孔温度变化不均,导致最后形成的斑点大小、数量发生变化。
3.6 ELISPOT 常见细胞及刺激剂

4. 检测抗体的加入与孵育
4.1整个实验过程都需要在超净台/生物安全柜中进行吗?
前期的包板、孵育、加样、刺激等操作,均需要保持操作环境无菌,此后都不强制要求保持无菌,检测抗体、显色液、缓冲液的加入均可在一般实验环境下进行。
4.2孵育条件?
在4℃保湿箱中储存18小时
5. 显色与读板
5.1 该技术可检测的斑点类型?
ELSPOT是基于酶标的显色原理,FluoroSpot是基于荧光的显色原理,所以最后的检测斑点会有所不同。
ELISPOT的酶标记物可以是HRP或者ALP
对应的显色底物分别是:BCIP/NBT、Fast red、TMB、AEC

FluoroSpot的荧光标记物较为常见的有FITC、CY3等

(优宁维提供AID酶联免疫斑点分析仪,在标配FITC、CY3通道之外,可根据标记物不同选配其他通道)
5.2 可以被判定为分泌了细胞因子的斑点有什么特点?如何避免误判?
真正的由于细胞因子分泌沉淀形成的斑点应具有致密的中心以及蛋白质扩散产生的轻外环,光斑大小在5000-10000平方微米;小而暗、边缘锋利、强度均匀、人工斑点与污垢、都不是真正的斑点。
因此,在使用软件进行结果评估时,需要为要计数的最小光斑尺寸设置不同分析的截止值,并且必须定义最大光斑尺寸以识别细胞簇,为每种不同的ELISPOT/FluoroSpot测定建立绝对设门标准。最小和最大“门”集将严重影响计数的点数。
5.3 产生条纹状斑点的原因?
首先,某些刺激触发趋化因子的释放,导致T细胞在孵育期间四处移动,在孔中产生细胞因子痕迹,当T细胞被多克隆刺激(如丝裂原和抗CD3 / CD28抗体)激活时尤其如此。
其次,细胞孵育过程中板的运动可能导致细胞滚动,从而产生不规则或长方形斑点。
5.4 成像结果出现小黑点的原因?
如果经过目视评估,这些“斑点”大小不一、高度不规则,则孔中可能存在灰尘颗粒。通过将 4-5 bar 的压缩空气吹入井孔中,可以轻松解决这个问题。
5.5 显色后检测板的干燥与储存条件?
显色结束后,应将去除封板膜,将检测板倒置,在室温(20-26℃)下避光干燥,以防止光照导致斑点漂白。
结语:
优宁维提供ELISPOT检测全流程解决方案:
样本制备相关试剂、耗材、仪器

检测试剂盒

AID 仪器设备

实验室检测服务
欢迎致电进行技术及产品咨询。
上海优宁维生物科技股份有限公司
试剂 | 耗材 | 仪器 | 软件 | 定制 | 实验服务 | 供应链
免费热线:4008-168-068
咨询邮箱:info@univ-bio.com
订购商城:www.univ-bio.com
微信公众平台:优宁维抗体专家,欢迎关注!
小优博士(小程序):5大课堂, 让你的科研不再难!



































